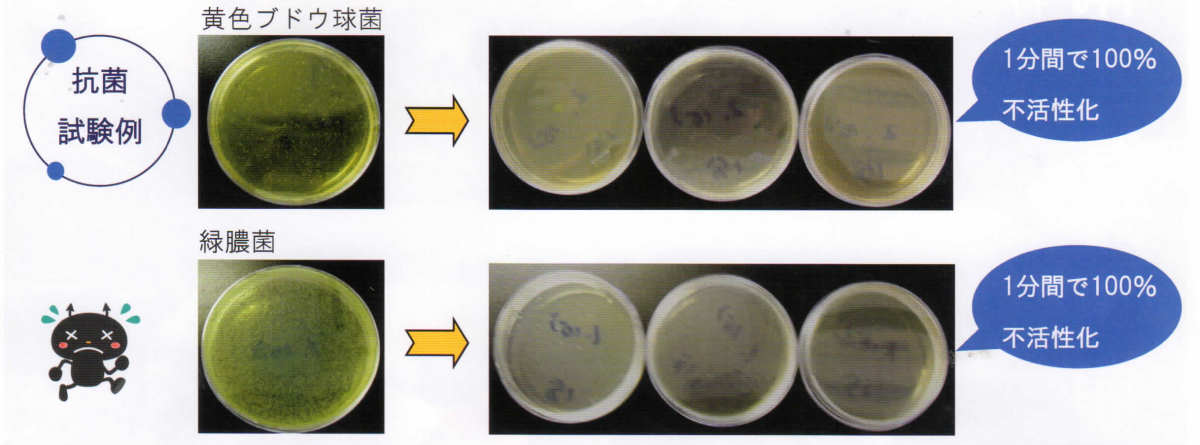

★室内環境分析受託
●法令による測定品目
| 学校環境衛生の基準 | |
官庁営繕部における平成15年度からのホルムアルデヒド等の室内空気中の化学物質の抑制に関する措置について | ホルムアルデヒド、トルエン、キシレン、エチルベンゼン、スチレン |
品確法 | ホルムアルデヒド、トルエン、キシレン、エチルベンゼン、スチレン |
掲示
★室内空気環境
除菌施工・衛生管理
次亜塩素酸水による施工
次亜塩素酸水は優れた除菌効果
※ 帯広畜産大学の研究により新型コロナウイルス不活化効果が証明されました。
また北海道大学とエナジック社との実験でも不活化が証明されました。
ほとんどの菌が不活化します。

オゾンによる除菌施工
奈良県立医科大学とMBTコンソーシアムの研究グループの実験により世界で初めてオゾンガス曝露による新型コロナウイルスの不活化が確認されました。
手順 : オゾン発生 ⇒ 分解 ⇒ 回収
※ 機器の運転時は無人となります。

★次亜塩素酸水生成装置
★ファインバブル
ファインバブル Finebubble Microbubble Nanobubble

イチゴ農家:収穫量が20~30%増加した。シーズン後半でも葉が青々している。
レタス水耕:成長が早くなった 90日⇒70日程度で出荷サイズになった。
路地野菜:成長が早く、明らかな成長促進効果がある。
トマト(水耕):根のはりがよくなった。
≪そのほか採用例≫
ニンニクスプラウト、プチトマト、小松菜、ガーベラ、植物工場(葉物野菜)

△養殖
n酸素の供給
n輸送効率化
n生物の生理活性(成長促進)
n病気予防
使用実例)ハマグリ畜養、
桜海老鮮度保持


【畜舎への提案】
糞尿汚水の処理 → アンモニアなど窒素化合物の除去、堆肥化
畜舎内噴霧 → 有害ウイルス・微生物殺菌、消臭
飲料水 → 健康保持・生体改善・排卵誘発
実例)烏骨鶏 の産卵頻度は10倍に増加
床洗浄 → 衛生管理・消毒殺菌・消臭

